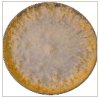
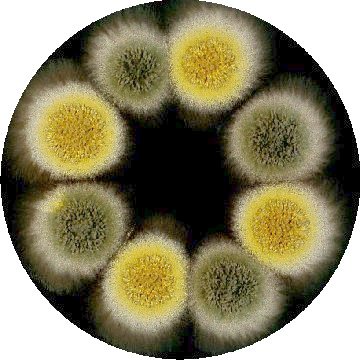
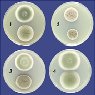
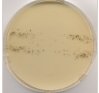
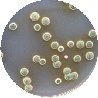

Image provided by A. Idnurm

Photo courtesy of A. Rossi, Genetics and Molecular Research 6:721-729

Click for large image





This image is from the Cereal Disease Lab

Mala Mukherjee et al. 2007; Microbiology 153:1734-1742


Additional photos (and vectors) available online
